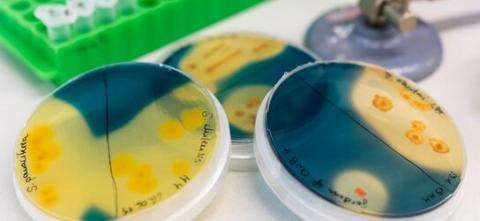
Verfahren zum Nachweis von Bakterienkulturen

Angewandte Naturwissenschaft
Der Studiengang Angewandte Naturwissenschaft umfasst die drei Disziplinen Physik, Chemie und Biotechnologie. Er verbindet eine breite naturwissenschaftliche Allgemeinbildung mit anwendungsorientierter Forschung und zielt auf fachübergreifende Kompetenzen und Lösungsstrategien.
Das Bachelorstudium vermittelt breit gefächerte naturwissenschaftliche Grundlagen mit hohem Praxisbezug. Auf diese Weise werden z.B. Biologinnen und Biologen ausgebildet, die auch Vorlesungen in Quantentheorie gehört haben. Und Physikerinnen und Physiker, die die Sauerstoffproduktion von Algen untersucht haben. Damit befähigt das Studium, sich schnell in komplexe interdisziplinäre Sachverhalte einzuarbeiten und kausale Zusammenhänge zu erkennen. Im späteren Berufsleben können die erworbenen Kenntnisse dann leicht auf eine Vielzahl anderer Problemstellungen übertragen werden.
Im Bachelorstudium wird die Entwicklung und Ausbildung sowohl von theoretischen als auch von praktischen Fähigkeiten und Kenntnissen gleichermaßen gefördert. In den ersten vier Semestern stehen solide Grundlagen in Mathematik, Physik, Chemie und Biologie im Vordergrund. Das fünfte und sechste Semester beinhaltet die sogenannte Vertiefungsphase, welche sich mit den individuell zusammenstellbaren Wahlpflichtmodulen sowie der Bachelorarbeit an den Masterschwerpunkten (Biotechnologie, experimentelle und theoretische Festkörperphysik, Halbleitertechnik) orientiert. In Vorbereitung auf die Bachelorarbeit erfolgt dabei die fachspezifische Vertiefung in einer ausgewählten Richtung.
Der Studiengang wurde daraufhin optimiert, dass nach dem erfolgreichen Abschluss des Bachelorstudiums und des Masterstudiums Angewandte Naturwissenschaft in den Vertiefungsrichtungen A "Umwelt-Biotechnologie-Analytik" oder B "Festkörperphysik" auch ein Seiteneinstieg ins Lehramt an Oberschulen in Sachsen möglich ist.
Anpassungen des aktuellen Lehrangebotes im Wahlpflichtbereich der Studiengänge können hier eingesehen werden.
- Fakultät
-
Fakultät 2 - Chemie, Physik und Biowissenschaften
- Abschluss
-
Bachelor of Science (B. Sc.)
- Regelstudienzeit
-
6 Semester
- Teilzeit möglich
-
Nein
- Studienbeginn
-
Wintersemester
- Zulassungsvoraussetzung
-
Abitur bzw. fachgebundene Hochschulreife oder eine als gleichwertig anerkannte Zugangsberechtigung
Sprachkenntnisse
- Bewerbung: mit mindestens B1-Niveau Deutsch
- Aufnahme des Fachstudiums: mit C1-Niveau Deutsch (z.B. DSH-2)
- Sprachkurse und DSH-Prüfung an der TUBAF
- Studienkolleg für internationale Studienbewerber
- Studiengangsprache
-
Deutsch
- Forschung und Entwicklung in der Halbleiterindustrie, wie z.B. bei Bosch, FCM, Global Foundries, Hanwha QCells, Infineon, Intel, Meyer Burger, Siltronic, TSMC, X-FAB usw.
- Kleine und mittelständische Unternehmen: Produktion und Dienstleistungen in naturwissenschaftlich-technischen Bereichen
- Forschung, Entwicklung und Management: Insbesondere fächerübergreifende Grundlagen- und angewandte Forschung und Entwicklung in der Physik, Chemie, Biotechnologie, Pharmazie, den Lebens- und Materialwissenschaften
- Kliniken, Labore, Institute großer Forschungseinrichtungen wie z.B. der Max-Planck- und Fraunhofer-Gesellschaft oder der Helmholtz- oder Leibniz-Gemeinschaft, Großforschungseinrichtungen
- Großindustrie: In Bereichen wie Umweltschutz, Vertrieb, Öffentlichkeitsarbeit, Patentwesen
- Seiteneinstieg ins Lehramt an Oberschulen in Sachsen für die Fächer Physik / Chemie
Imagefilm Angewandte Naturwissenschaft
Interessen und Fähigkeiten, die Sie mitbringen sollten
- Interesse an den naturwissenschaftlichen Fächern Biologie, Physik und Chemie
- Interesse an fächerübergreifenden Zusammenhängen
- grundlegendes mathematisches Verständnis
Warum Angewandte Naturwissenschaft an der TUBAF studieren?
Wenn Sie sich für alle Naturwissenschaften interessieren, und sich die Möglichkeit eines direkt anschließenden, deutschsprachigen Masterstudiums mit verschiedenen Spezialisierungsrichtungen offenhalten möchten, bietet Ihnen die TUBAF mit dem Studiengang „Angewandte Naturwissenschaft“ einen deutschlandweit einzigartigen Studiengang! Hier können Sie ein tiefgreifende, naturwissenschaftliche Kenntnisse und Fertigkeiten erwerben, um an den großen Herausforderungen unserer Zeit arbeiten – von der Energieerzeugung, -speicherung und -wandlung über die Nano- und Mikroelektronik bis zur Biotechnologie. Und das alles in einer familiären Atmosphäre mit idealen Betreuungsverhältnissen.
Infos zu weiterführenden Studiengängen an der TUBAF
Für Studierende im Bachelor Angewandte Naturwissenschaft ist ein Platz im aufbauenden Masterstudiengang „Angewandte Naturwissenschaft“ garantiert. Hier kann eine der vier Vertiefungsrichtungen
- Umwelt - Biotechnologie – Analytik
- Festkörperphysik
- Halbleitertechnik und Photovoltaik
- Theorie der Elektronenstruktur von Materialien
belegt werden. Natürlich bleibt auch weiterhin die Möglichkeit einer fächerübergreifenden Modulwahl bestehen.
Falls Sie entscheiden, sich ganz auf die Chemie konzentrieren zu wollen, können Sie auch Ihr Studium im Masterstudiengang „Chemie“ fortsetzen. Im internationalen, englischsprachigen „Advanced Materials Analysis“ hingegen können Sie sich ganz auf die Gebiete der Material- und Werkstoffanalytik vertiefen.
Beim NAT-Studium setzt man sich mit sehr verschiedenen und immer wieder neuen Themengebieten auseinander. So baut man sich ein sehr breit aufgefächertes Wissen auf. Diese dynamische Ausbildung bereitet einen optimal auf forschungs- und industrienahe Berufsfelder vor.
Dr. Patrick Hofmann - Development Engineer bei der Freiberger Compound Materials GmbH
Ich habe Angewandte Naturwissenschaften studiert, weil es breiter gefächert als ein reiner Chemie-Studiengang ist. Außerdem hat mir gefallen, dass die Uni nicht so groß ist und man eine persönliche Beziehung zu den Betreuern bekommt.
M.Sc. Sandra Jankus - Entwicklungsingenieurin bei der Frolyt GmbH in Freiberg
Ein Studium, welches die Grundlagen in Chemie, Biologie, Physik und Mathe vermittelt. Somit musste ich mich nicht direkt für ein Fach entscheiden. Außerdem hat die TU Bergakademie einen guten Ruf, was die Betreuende-zu-Studierenden Quote anbelangt, und die Chance auf gute Laborplätze.
Dr.-Ing. NAT Caroline Hommel - wissenschaftliche Mitarbeiterin im Centerfor Quantum Nanoscience in Seoul, Südkorea
Impressionen
Aktuelle Einblicke ins Studium gibt's auf den Social-Media-Kanälen der Fakultät für Chemie und Physik: Instagram @tubaf_nat und TikTok @tubaf_nat